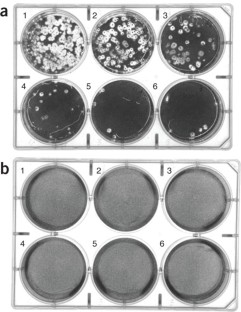

Abstract
Protocols for the synthesis of the microbicidal polycation N,N-dodecyl,methyl-polyethylenimine and coating (painting) of glass slides with this polycation's butanol solution are described. Subsequently detailed are the procedures for validating that the resultant coated slides are essentially 100% lethal to the human bacterial pathogens, Staphylococcus aureus and Escherichia coli, as well as to two common strains of influenza virus. The time required to prepare and apply the cationic polymer and to test its microbicidal efficiency is conservatively estimated to be <4 weeks.
This is a preview of subscription content, access via your institution
Access options
Subscribe to this journal
Receive 12 print issues and online access
$259.00 per year
only $21.58 per issue
Buy this article
- Purchase on SpringerLink
- Instant access to the full article PDF.
USD 39.95
Prices may be subject to local taxes which are calculated during checkout

Similar content being viewed by others
References
Edge, M., Allen, N.S., Turner, D., Robinson, J. & Seal, K. The enhanced performance of biocidal additives in paints and coatings. Progr. Org. Coat. 43, 10–17 (2001).
Klibanov, A.M. Permanently microbicidal materials coatings. J. Mater. Chem. 17, 2479–2482 (2007).
Lewis, K. & Klibanov, A.M. Surpassing nature: rational design of sterile-surface materials. Trends Biotechnol. 23, 343–348 (2005).
Miloviæ, N.M., Wang, J., Lewis, K. & Klibanov, A.M. Immobilized N-alkylated polyethylenimine avidly kills bacteria by rupturing cell membranes with no resistance developed. Biotechnol. Bioeng. 90, 715–722 (2005).
Park, D., Wang, J. & Klibanov, A.M. One-step, painting-like coating procedures to make surfaces highly and permanently bactericidal. Biotechnol. Prog. 22, 584–589 (2006).
Haldar, J., An, D., Álvarez de Cienfuegos, L., Chen, J. & Klibanov, A.M. Polymeric coatings that inactivate both influenza virus and pathogenic bacteria. Proc. Natl. Acad. Sci. USA 103, 17667–17671 (2006).
Campbell, N.A. & Reece, J.B. Biology 7th edn (Benjamin Cummings, San Francisco, California, 2005).
Choppin, P.W. & Compans, R.W. The structure of influenza virus. in The Influenza Viruses and Influenza (ed. Kilbourne, E.D.) 15–51 (Academic, New York, 1975).
Ge, Q. et al. RNA interference of influenza virus production by directly targeting mRNA for degradation and indirectly inhibiting all viral RNA transcription. Proc. Natl. Acad. Sci. USA 100, 2718–2723 (2003).
Acknowledgements
This work was financially supported by the United States Army through the Institute for Soldier Nanotechnologies at the Massachusetts Institute of Technology (MIT) under contract DAAD-19-02-D-0002 with the Army Research Office. The content of this article does not necessarily reflect the position of the United States Government, and no official endorsement should be inferred. We are grateful to Professor Jianzhu Chen of the MIT Biology Department for invaluable help in, and permission to use his laboratory for, influenza virus work.
Author information
Authors and Affiliations
Corresponding author
Rights and permissions
About this article
Cite this article
Haldar, J., Weight, A. & Klibanov, A. Preparation, application and testing of permanent antibacterial and antiviral coatings. Nat Protoc 2, 2412–2417 (2007). https://doi.org/10.1038/nprot.2007.353
Published:
Issue date:
DOI: https://doi.org/10.1038/nprot.2007.353
This article is cited by
-
Effect of DMPEI coating against biofilm formation on PVC catheter surface
World Journal of Microbiology and Biotechnology (2024)
-
Recent Advances in Superhydrophobic and Antibacterial Cellulose-Based Fibers and Fabrics: Bio-inspiration, Strategies, and Applications
Advanced Fiber Materials (2023)
-
Antimicrobial properties of a multi-component alloy
Scientific Reports (2022)
-
Antiviral surfaces and coatings and their mechanisms of action
Communications Materials (2021)
-
Copper-containing glass ceramic with high antimicrobial efficacy
Nature Communications (2019)


